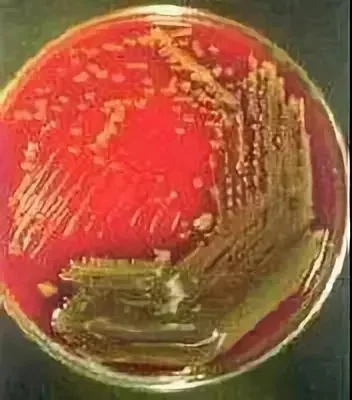
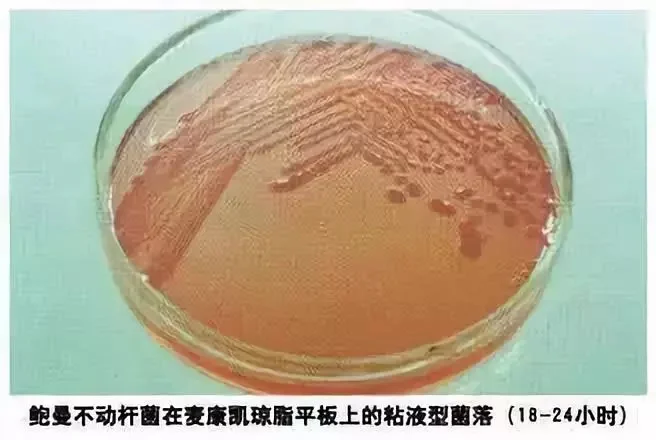

延禧攻略:高贵妃究竟死于哪种细菌感染
原标题:延禧攻略:高贵妃究竟死于哪种细菌感染? 有没有人在追《延禧攻略》? 该古装剧一改往日女主纯良
原标题:延禧攻略:高贵妃究竟死于哪种细菌感染?
有没有人在追《延禧攻略》?
该古装剧一改往日女主纯良无辜小白兔的人设,一路打怪升级,战斗力爆表。
成了这段时间大家热议的头号大剧!
在剧中,高贵妃就是嚣张跋扈的代名词,明明只是一个贵妃,却演出了皇太后的气势,屡屡将毒手伸向皇子......
比如,泥萌最爱的?五阿哥~

战斗女主终于按捺不住,在某次高贵妃在与皇上观看打铁花表演时,借着?万紫千红的戏用铁水烫伤了高贵妃的后背,更惨的是铁水被有心之人混进了金汁,使得高贵妃的病情日渐恶化,最后自杀领盒饭走人......

看到这里,很多人要问:金汁为何物?为什么这么厉害?
金汁名字看似很高大上,实质却是最原始污秽,它是最肮脏的粪便和尿液熬成的金色浓稠汤汁。

那么问题来了,粪便有这么大的杀伤力吗?
铁的熔点有 1,535 ℃,虽然粪便中含有大量细菌,但高温不是能灭菌吗?
按照铁水的高温,往铁水里加入粪水,那些细菌命再硬也早就被杀死了,还有什么能力害人?

对,实际上,金汁的作用很纯粹,就是想恶心你,心理上膈应你。
高贵妃真正死因是烫伤创面细菌感染,和有没有混入金汁关系不大。
人一但被烧伤,皮肤屏障功能受损,创面渗出的体液及坏死组织会成为细菌的良好培养基,很容易造成感染,在那个没有抗生素的时代,这都是分分钟要命的。
也有网友感叹了,高贵妃要是活在现代,就不会被感染了,一定能活到全剧终。
那么,一定是这样吗?
像高贵妃被超高温度的铁水大面积烫伤,往往导致全层皮肤的深度烧伤(医学上称为 Ⅲ 度烧伤),非常严重,救治难度很高。
就算高贵妃活在现代,医院各种有创检查和治疗(如气管切开、留置导尿、动静脉置管等)、血液制品的输入、和抗菌素长时间全身应用都是会可引发或导致感染。
如果不幸的再感染?超级细菌,再加上像高贵妃这样?不配合的病人,高贵妃还是有可能会全身感染而亡!

那么被烫伤的高贵妃最可能感染的病菌有哪些呢?
1.铜绿假单胞菌
大面积烧伤创面感染最常见的细菌是铜绿假单胞菌,本菌属于非发酵革兰氏阴性杆菌。
菌体细长且长短不一,菌体的一端有单鞭毛,在暗视野显微镜或相差显微镜下观察可见细菌运动活泼。
本菌为专性需氧菌,生长温度范围 25~42 ℃,最适生长温度为 25~30 ℃,该菌有 4 ℃ 不生长而在 42 ℃ 可以生长的特点。
在普通培养基上可以生存并能产生水溶性的色素,如绿脓素(pyocynin)与带荧光的水溶性荧光素(pyoverdin)等,在血平板上会有透明溶血环。
铜绿假单胞菌能产生多种致病物质,主要是内毒素、外毒素、蛋白分解酶和杀白组胞素等。
其致病特点是引起继发感染,多发生在机体抵抗力降低时,如大面积烧伤,长期使用免疫抑制剂等。
临床上常见的有皮肤和皮下组织感染,中耳炎、脑膜炎、呼吸道感染、尿道感染、败血症等。
铜绿假单胞菌具有多重耐药的特性,能天然抵抗多种抗生素,对抗生素耐药有多种耐药机制,如产生的多种 β 内酰胺酶、产氨基糖苷类钝化酶、细菌细胞外膜蛋白改变使抗菌药进入菌体的量减少、细菌细胞膜上存在多种外排泵以及细菌旋转酶或拓扑异构酶发生改变等。
在治疗铜绿假单胞菌的感染过程中,一方面充分考虑其耐药机制,选用耐药率低的药物,避免诱导铜绿假单胞菌产生 β 内酰胺酶而对抗菌药物广泛耐药。
另一方面,由于长期的各种抗生素治疗,分离菌株可能发生耐药性的改变,因此,初次分离的敏感菌株在治疗 3~4 d 后应重新培养做药敏试验。
2.金黄色葡萄球菌

金黄色葡萄球菌为革兰染色阳性球菌,直径约 1 μm,排列成葡萄串状,无芽胞,无鞭毛,不能运动。
大多数无荚膜。
平板上菌落厚、有光泽、圆形凸起,直径 0.5~1.0 mm。
血平板菌落周围形成透明的溶血环。
常引起皮肤组织化脓性感染,金黄色葡萄球菌产生的多种外毒素也可引起败血症及脓毒血症,是医院感染的主要病原菌。
随着抗生素的广泛滥用,耐药的金黄色葡萄球菌开始出现并逐年增多,现已遍及全球,其中耐甲氧西林金黄色葡萄球菌(MRSA),也称超级细菌。
除甲氧西林外,MRSA 对其他所有与甲氧西林结构相似的 β-内酰胺类抗生素以及氨基糖苷类、四环素类、氟喹诺酮类等药物均有不同程度耐药,使得抗感染的难度大大增加。
3.大肠埃希菌

大肠埃希菌为革兰氏阴性短杆菌,大小 0.5 × 1~3 μm。
周生鞭毛,能运动,无芽孢。
目前,大肠埃希菌已成为医院感染的重要机会致病菌之一,当机体抵抗力下降时可引起人体各部位内源性感染。
比如大面积烧伤的人,大肠杆菌侵入血流,会引起败血症。
近年来,随着抗生素应用的日益增多,特别是许多广谱抗生素及新型抗生素的广泛应用,细菌的耐药性日益严重,多重耐药的肠杆科细菌对全球健康的威胁与日俱增。
产超广谱 β 内酰胺酶(ESBL)和碳青霉烯酶是菌株耐药的常见原因。
4.鲍曼不动杆菌
鲍曼不动杆菌为革兰阴性球杆菌,单个或成双排列,有时呈丝状或链状。
无芽胞,无鞭毛,革兰染色不易脱色。
在血琼脂平板上 35℃
培养 18~24 h ,形成直径 2~3 mm 、圆形、灰白色、光滑、边缘整齐的菌落,部分菌落呈黠液状。
在麦康凯琼脂等平板上 35 ℃ 培养 18~24 h ,形成粉红色菌落, 48 h 后菌落呈深红色,部分菌株呈黠液型菌落。
鲍曼不动杆菌是条件致病菌,广泛存在于自然界。
该菌对湿热紫外线及化学消毒剂有较强抵抗力,常规消毒只能抑制其生长而不能杀灭,因此,在医院,患者机体抵抗力下降加上各种侵入性操作和长期使用广谱抗生素治疗,一些不动杆菌伺机而动,趁机占领?阵地且产生了耐药性,逐步成为医院感染的重要病原菌,主要引起呼吸道感染,也可引发败血症、泌尿系感染、继发性脑膜炎等,对危重患者威胁很大。
特别是耐碳青霉烯类的鲍曼不动杆菌,发展迅猛,甚至出现?全耐药的鲍曼不动杆菌,已引起临床和微生物学者的严重关注。
抗生素的出现如奇迹一样帮人类解决了无数的问题,使人类在与众多疾病的战斗中能够占主导地位。
但近几年,抗生素的错误及过度使用,造成了耐药菌和多重耐药菌的泛滥,对人类构成的威胁也越来越大。
因此,即便是活在现代,高贵妃依然难逃厄运。
PS:
想一睹女主芳容?
其实是这个样子滴......
(魏姐粉丝后援会求放过)
本文来自?检验医学。
作者徐瑞平,河南省镇平县第二人民医院检验科。
